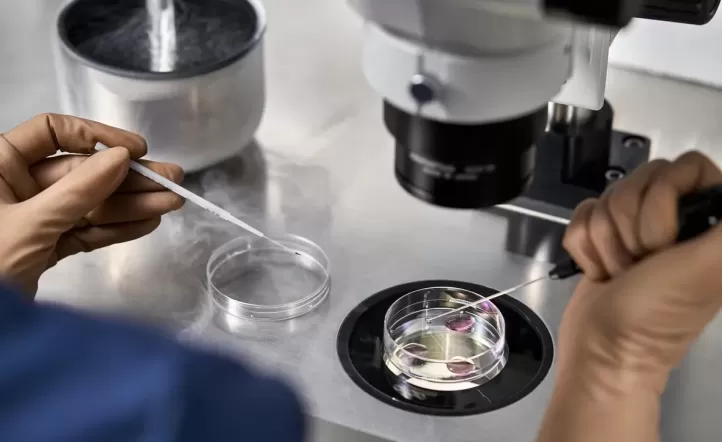

Una pareja tuvo un bebé con un embrión que no era suyo por un error médico
Había sido fecundado in vitro en una clínica de fertilidad. El padre advirtió cuando el niño nació que el grupo sanguíneo era incompatible con el suyo y el de su mujer.
Una pareja tuvo a su tercer hijo en San Isidro y cuando estaba por dejar la clínica, el padre del bebé advirtió que algo no estaba bien: el grupo sanguíneo no se correspondía con los de él y su mujer. Si el registro era correcto, con ese grupo y factor no podía ser genéticamente su hijo.
Hicieron entonces un nuevo análisis de sangre y se confirmó el primer resultado. Para erradicar cualquier duda, un médico les recomendó un estudio de ADN, que volvió a ratificar la incompatibilidad.
La pareja se había hecho un tratamiento de fertilización in vitro, pero como no habían recurrido a donación de óvulos ni de espermatozoides, el embrión debía tener material genético únicamente de ellos. La sospecha, desde el primer momento, fue que en la clínica de fertilidad, por error, a la mujer se le había transferido el embrión de otra pareja.
La justicia penal abrió una investigación para determinar si hubo algún delito. Se tramitó en una fiscalía correccional de San Isidro, tras la denuncia de la pareja que había tenido el bebé, por los presuntos delitos de supresión de identidad, estafa y lesiones. Con intervención de la Policía Federal Argentina, se allanaron el sanatorio en el que nació el niño –para hacerse de la historia clínica- y el instituto de fertilidad.
Los investigadores consideraron que el problema estuvo en el instituto. Las personas a quienes podría corresponderles en realidad el embrión están al tanto de la situación y están ahora bajo estudio para determinar a quién pertenecía. Así lo informaron fuentes que conocen lo que pasa puertas adentro de la institución, que precisaron que el óvulo que dio origen al embrión habría sido donado y que resta determinar quién es el padre biológico entre un reducido grupo de clientes del centro de fertilidad.
En cuanto al embrión que debieron haberle colocado a la pareja que tuvo el bebé, les informaron que no resultó ser apto para ser implantado, relataron fuentes del caso. Esto descartaría la posibilidad de que, con una confusión doble, haya nacido un niño del embrión de ellos.
Vadim Mischanchuk, penalista, es el abogado del centro de fertilidad. Dijo al diario La Nación: “Nos pusimos a disposición de la Policía y la Justicia. Cuidando tanto a la familia que tuvo al bebé como al resto de las personas involucradas, se tomaron las medidas que consideramos necesarias”. En cuanto a la falla del instituto, afirmó que no pudieron precisar dónde estuvo: “Se repasó el protocolo una y cien veces y no se encontró dónde se pudo haber producido esta situación”.
La causa penal se cerró. La Justicia llegó a la conclusión de que habría existido un error en el tratamiento médico; sin dolo, no pueden configurarse los delitos de supresión de identidad ni de estafa, y no se corroboraron por ahora lesiones. La fiscalía, entonces, desestimó el caso, pero dio intervención al fuero de familia y al asesor de menores e incapaces, informaron fuentes judiciales.
Caso único
Se trata del primer caso de este tipo que se conoce en la Argentina. En materia de filiación puede convertirse en un asunto de gran complejidad determinar a quiénes corresponde reconocer como los padres del niño (que fue inscripto como hijo de la mujer que lo gestó y su pareja). No se trata de un embrión donado y existía voluntad procreacional en las dos familias. Marisa Herrera, abogada especialista en derecho de familia, explicó que, de plantearse una controversia, “la gran pregunta es la socioafectividad” para determinar qué resulta mejor para el niño. En paralelo con la filiación, esto puede dar lugar a una demanda por daños y perjuicios, añadió.
Herrera relató que existió un caso similar en Italia. “El 8 de octubre del 2014, el Tribunal de Roma dictó el primer fallo a nivel mundial en un supuesto de intercambio de embriones. Al momento de proceder con la implantación, por error médico, se entrecruzaron los embriones: en el útero de cada mujer se implantó el embrión del material genético de la otra pareja y una tuvo un embarazo de gemelos. La otra pareja demandó para que, cuando nacieran los niños, se los entregaran por ser ellos los padres genéticos, pero el Ministerio Público rechazó la solicitud al considerar que era interés de los niños no ser separados de la madre biológica por aplicación del adagio ‘madre siempre cierta es’, y porque el ordenamiento jurídico italiano establece que la determinación de la maternidad deriva del parto”, relató Herrera al diario La Nación.
“En el mismo sentido –explicó la abogada- el Tribunal de Roma rechazó la demanda. Argumentó que en el derecho actual la filiación se ha ido apartando paulatinamente de la pertenencia genética. Además, señaló que, por el interés de los niños, era importante mantener el vínculo generado con la pareja demandada, porque los bebés habían forjado una relación afectiva con esos padres”.
En ese mismo fallo, relató Herrera, el tribunal romano les reconoció no obstante a los demandantes el daño sufrido y, por ende, el derecho a reclamar una indemnización por el “error inexcusable” del que habían sido víctimas.
(Fuente: La Nación)

Dejá tu comentario